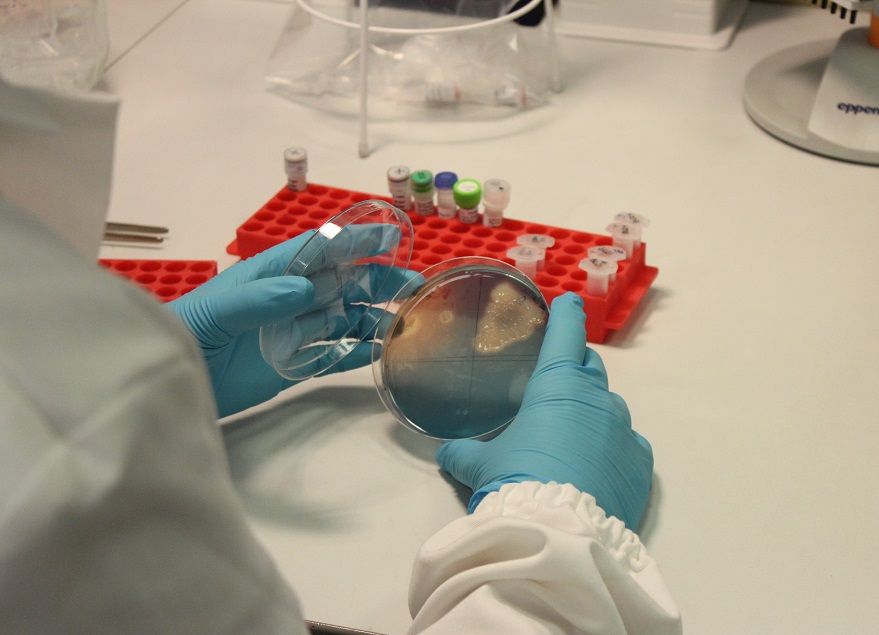
Fig. 1: Analisi microbiologiche nel Laboratorio di Biologia Molecolare © Centro di Sperimentazione Laimburg

News
Contatto
Julia Rizzo
Contatto stampa per i media in lingua italiana
Johanna Höller
Contatto stampa per i media in lingua tedesca
Centro di Sperimentazione Laimburg: pubblicato il Programma di attività 2023 con 355 progetti di ricerca - Circa il 60 per cento dei nuovi progetti proviene da organizzazioni e aziende locali
È proprio l’accordo tra scienza e pratica che rende la ricerca del Centro di Sperimentazione Laimburg vicina ai bisogni della pratica agricola e industriale agroalimentare del territorio. Ogni anno oltre 145 rappresentati dei gruppi di interesse di questi settori vengono invitati a contribuire attivamente alla stesura del Programma annuale di attività del Centro. Dei 42 nuovi progetti, circa il 60% proviene da proposte esterne. Il Programma di attività 2023 del Centro Laimburg comprende in totale 355 progetti e attività ed è stato pubblicato sul sito web istituzionale.
15/02/2023

Agricoltura montana: lanciato un progetto paneuropeo a sostegno dei pascoli
Per contrastare il calo della pratica del pascolo in tutta Europa, è stato lanciato il progetto Horizon Europe Grazing4Agroecology (G4AE), coordinato dal Centro per i prati e pascoli della Bassa Sassonia e che coinvolge 18 partner in tutta Europa. Esso mira a supportare allevatori e pastori nell’estendere l’uso del pascolamento come pratica benefica per l’ambiente, gli animali e la società. Il Centro di Sperimentazione Laimburg e Bioland Alto Adige sono partner di progetto e si occuperanno di raccogliere e implementare le migliori pratiche e le innovazioni per promuovere il pascolo a livello locale in una prospettiva agroecologica.
02/02/2023

Una nuova frontiera per l’agrivoltaico: lanciato il progetto di ricerca SYMBIOSYST
Conciliare fotovoltaico e agricoltura per abbattere le emissioni, tutelare il paesaggio e sostenere l’economia
23/01/2023

EUFRIN, la rete europea per il sostegno alla ricerca e allo sviluppo in frutticoltura, compirà 30 anni
EUFRIN è un network di rappresentanti della ricerca e delle università in 25 Paesi europei, che ha lo scopo di far fronte comune per sostenere la ricerca scientifica e lo sviluppo di tecnologie nell’ambito della frutticoltura. Obiettivo è una produzione efficiente e sostenibile di frutta di qualità. Quest’anno il network, riunitosi nell’ambito della fiera Interpoma, è stato presieduto dal Centro di Sperimentazione Laimburg e ha messo il focus sulla digitalizzazione in frutticoltura, un trend in rapida crescita, che porterà grandi novità in futuro.
01/12/2022

Le complesse interazioni tra fitoplasmi e insetti vettori in relazione agli “scopazzi del melo”
Katrin Janik ha studiato biologia con particolare attenzione alla microbiologia, alla biochimica e alla virologia, specializzandosi in biologia delle malattie infettive durante il dottorato. Al Centro Laimburg dirige il gruppo di lavoro Genomica Funzionale per approfondire la funzione dei geni in piante e batteri, con particolare attenzione per quelli di importanza economica per l’agricoltura altoatesina. Centrale per la ricerca odierna sono gli “scopazzi del melo”, una malattia infettiva causata da fitoplasmi e che provoca ingenti danni economici in Alto Adige da oltre 20 anni.
23/11/2022
Interpoma 2022: il Centro Laimburg presenta risultati della ricerca, dalla digitalizzazione nei frutteti al controllo biologico dei parassiti
Al via la 12^ edizione di Interpoma, la fiera internazionale leader mondiale per l'industria della mela. Il Centro di Sperimentazione Laimburg è tra i protagonisti con uno stand nel quale presenta diversi progetti e risultati di ricerca, dalla digitalizzazione nei frutteti al controllo biologico dei principali parassiti, alla gestione dei danni fisiologici nel postraccolta delle mele. Nuovo coordinatore del congresso della fiera è Walter Guerra, l’esperto pomologo e responsabile dell’Istituto di Frutti- e Viticoltura del Centro di Sperimentazione Laimburg.
17/11/2022

Tecniche genetiche green: parliamone! Potenziale, opportunità e rischi per un’agricoltura sostenibile
Incroci, mutagenesi, ingegneria genetica classica e genome editing: la coltivazione di piante in agricoltura senza modifiche del genoma non esiste. Per migliaia di anni, l'uomo ha alterato, consapevolmente o inconsapevolmente, il materiale genetico delle piante a proprio vantaggio. Sono pochi gli argomenti dove l’opinione pubblica e il parere degli esperti divergono così tanto, come sul tema delle tecniche genetiche verdi. Il Centro di Sperimentazione Laimburg e la Libera Università di Bolzano invitano a un dialogo con gli scienziati su questo tema. Durante l’evento sarà possibile porre domande anche in forma anonima tramite WhatsApp. L'evento si terrà lunedì 14 novembre 2022, alle ore 17.00, presso il NOI Techpark (sale seminari).
08/11/2022

Agricoltura smart: inaugurato il primo laboratorio a cielo aperto in frutti- e viticoltura in Alto Adige, LIDO – Laimburg Integrated Digital Orchard
LIDO – Laimburg Integrated Digital Orchard è il primo laboratorio a cielo aperto in frutti- e viticoltura in Alto Adige, inaugurato oggi in occasione di una conferenza stampa e di un open day presso il Centro di Sperimentazione Laimburg. Innovativo, smart e focalizzato sulla sostenibilità, LIDO ha come obiettivo quello di promuovere l'innovazione nel campo della digitalizzazione e della robotica in agricoltura. Da oggi, LIDO è a disposizione di aziende e istituti di ricerca per utilizzare, testare e dimostrare al pubblico tecnologie esistenti e nuove. LIDO è stato finanziato dal Fondo europeo di sviluppo regionale (FESR 2014–2020, “Investimenti a favore della crescita e dell’occupazione”).
25/10/2022

Presentato il nuovo Laimburg Report 2020-2021: una raccolta dei dati e fatti salienti tra organizzazione, sperimentazioni e progetti di ricerca
Negli ultimi anni, nonostante la pandemia da Covid-19, il Centro di Sperimentazione Laimburg ha aumentato la sua capacità di ricerca, lavorando a un numero maggiore di progetti e sperimentazioni, incrementando le pubblicazioni scientifiche e i risultati di ricerca ottenuti. Oggi è stata presentata la nuova edizione del Laimburg Report, una raccolta di relazioni scientifiche selezionate, dati, fatti e curiosità sul Centro per il biennio 2020-2021. La pubblicazione contiene collegamenti ipertestuali a file multimediali ed è disponibile in tre versioni linguistiche, sia in versione cartacea che nel nuovo formato digitale navigabile su https://report.laimburg.it/ .
19/10/2022

Ricerca scientifica in agricoltura montana: presentati nuovi risultati scientifici al Convegno sulle erbe aromatiche del Centro Laimburg
Gli studi sull'idoneità di diverse varietà di melissa alla coltivazione in zone montane e le ultime indagini sulla biodiversità nelle aree di coltivazione delle erbe: questi due dei sette temi trattati al primo Convegno sulle erbe aromatiche del Centro di Sperimentazione Laimburg, organizzato in collaborazione con la Camera dell'Agricoltura del Tirolo e la Fondazione Edmund Mach. Obiettivo dell'evento è promuovere lo scambio scientifico e trasmettere agli agricoltori nuove scoperte sulla coltivazione delle erbe. Per l’agricoltura montana si tratta di un'interessante coltura di nicchia.
13/10/2022
